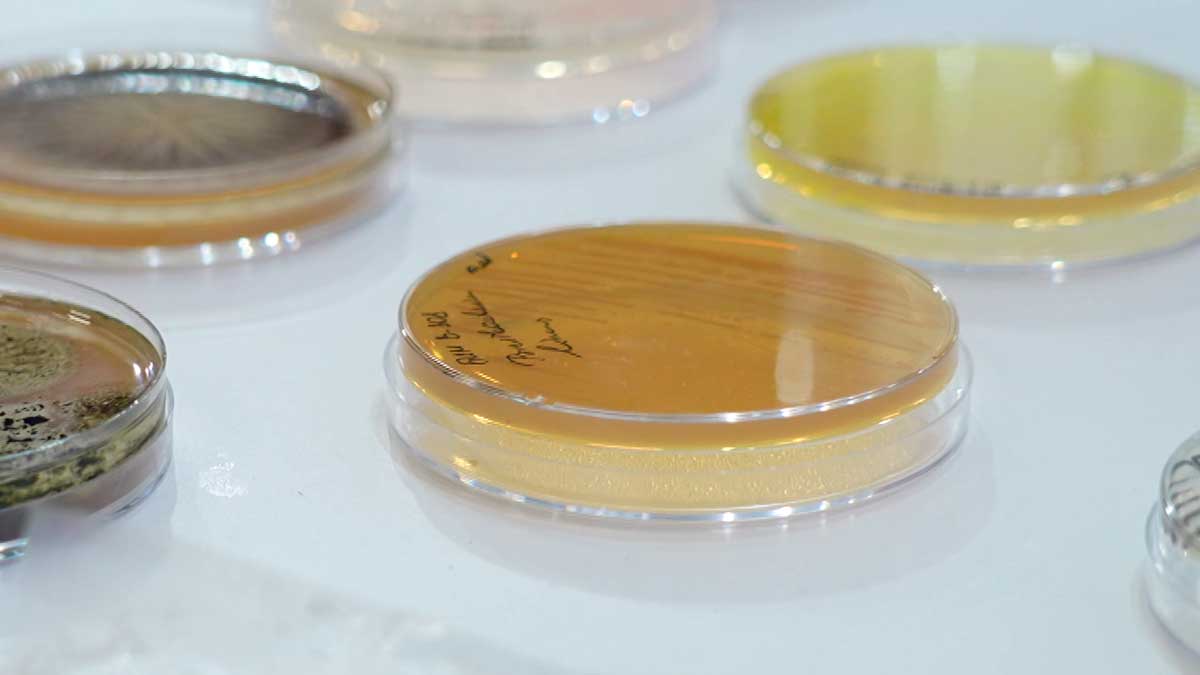
На выставке «Моя Беларусь» представлена уникальная площадка НАН о микробиологии

11 февраля, 2026 23:02
11 февраля, 2026 21:34
11 февраля, 2026 17:48
11 февраля, 2026 17:38
11 февраля, 2026 16:15
11 февраля, 2026 15:55
11 февраля, 2026 15:31
11 февраля, 2026 14:55
11 февраля, 2026 14:35
11 февраля, 2026 12:05
11 февраля, 2026 11:50
11 февраля, 2026 10:35
10 февраля, 2026 21:54
10 февраля, 2026 21:09
10 февраля, 2026 17:58
Объединение сил специальных операций в Бресте приведена в повышенную готовность во время проверки ВС
10 февраля, 2026 15:05
10 февраля, 2026 14:40
10 февраля, 2026 12:05
10 февраля, 2026 11:40
10 февраля, 2026 11:31
10 февраля, 2026 09:45
10 февраля, 2026 09:30
10 февраля, 2026 09:15
10 февраля, 2026 09:00
9 февраля, 2026 21:57
9 февраля, 2026 21:28
9 февраля, 2026 21:20
9 февраля, 2026 21:16
9 февраля, 2026 16:35
9 февраля, 2026 15:50
9 февраля, 2026 15:05
9 февраля, 2026 12:10
9 февраля, 2026 11:46
9 февраля, 2026 11:37
9 февраля, 2026 11:02
9 февраля, 2026 10:35
9 февраля, 2026 10:07
9 февраля, 2026 09:36
7 февраля, 2026 22:14
7 февраля, 2026 22:10
7 февраля, 2026 21:50
7 февраля, 2026 21:34
7 февраля, 2026 14:50
6 февраля, 2026 21:38
6 февраля, 2026 14:56
6 февраля, 2026 14:33
6 февраля, 2026 10:21
6 февраля, 2026 09:41
5 февраля, 2026 21:45
5 февраля, 2026 21:15
5 февраля, 2026 15:28
5 февраля, 2026 15:06
5 февраля, 2026 14:48
5 февраля, 2026 14:38
5 февраля, 2026 11:46
5 февраля, 2026 11:33
5 февраля, 2026 09:25
4 февраля, 2026 22:20
4 февраля, 2026 21:34
4 февраля, 2026 21:08
4 февраля, 2026 15:23
4 февраля, 2026 14:54
4 февраля, 2026 14:36
4 февраля, 2026 12:05
4 февраля, 2026 11:45
4 февраля, 2026 11:35
4 февраля, 2026 09:55
4 февраля, 2026 09:18
3 февраля, 2026 22:39
3 февраля, 2026 22:16
3 февраля, 2026 17:45
3 февраля, 2026 17:30
3 февраля, 2026 14:48
3 февраля, 2026 11:38
3 февраля, 2026 09:20
3 февраля, 2026 09:10
2 февраля, 2026 22:12
2 февраля, 2026 21:44
2 февраля, 2026 21:32
2 февраля, 2026 17:50
2 февраля, 2026 14:50
2 февраля, 2026 14:45
2 февраля, 2026 14:35
2 февраля, 2026 11:45
2 февраля, 2026 11:40
2 февраля, 2026 11:38